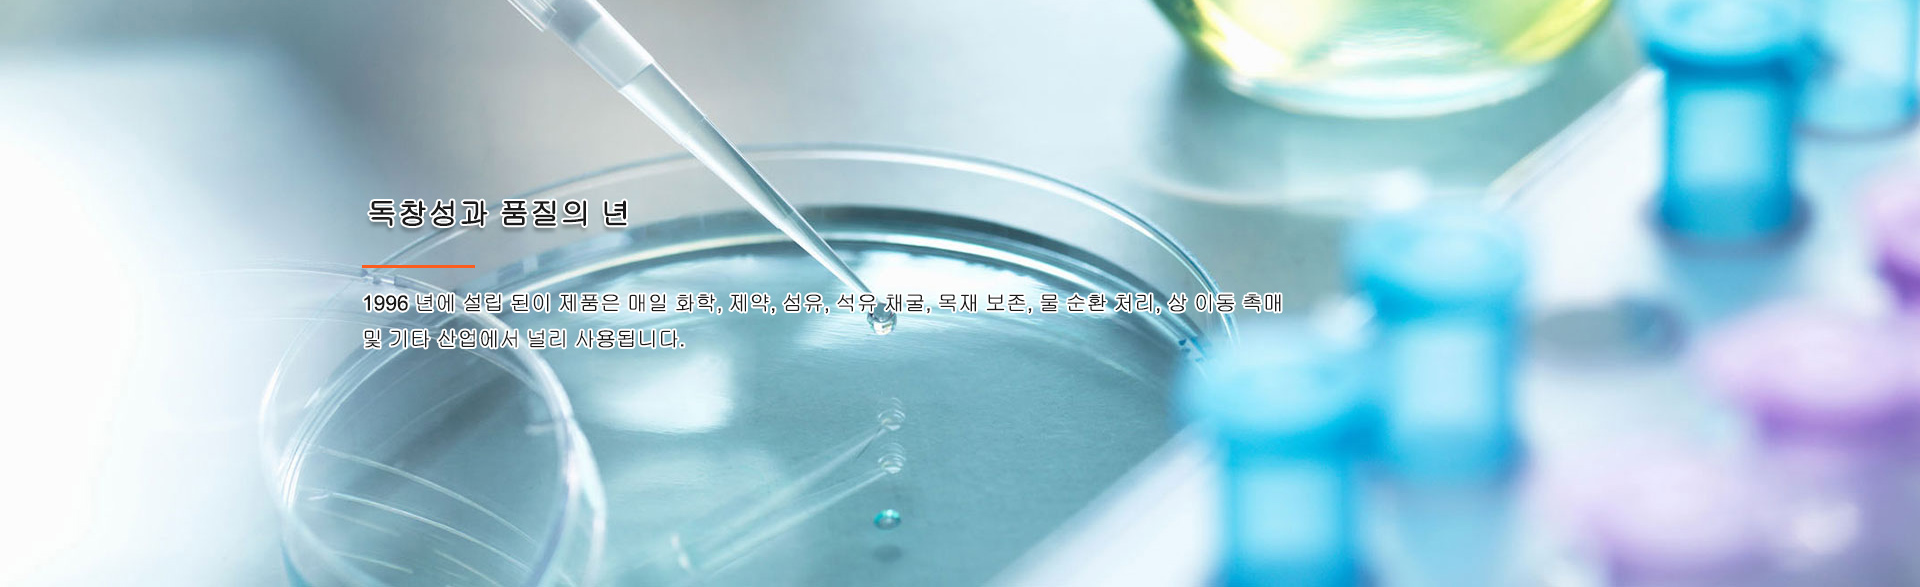

?? ??????

?? ??

?? ??

?? ??
??
? ??? ?? ?? ??? ?? ??? ? ?? ? ??? ???? ??, ?? ? ??? ???, ?? ??, ?? ?? ????, 1- ?? ????, 2- ?? ????, ???? ?? S ??? ?? ? ??? ???? ????.

???
?? EC ?? ?? ?? ??
?? ? ??? ??? ??? ??? ? ?? ??? ??? ?? ???? ???, ?? ? ??? ? ???? ???? ?? ???, ?? ??, ?? ??, ???? ?? ??? ?? ?? ??? ??? ????.


??? ??
?? ?? / ?? ??? ?? ????? ?? ?? ??
?? ??? ?? ? ?? ??, ?? ?? ??, ?? ???? ???? ?? ???? ???? ???? ??? ??? ? ????.


?? ??
鵬辰新材料科技股份有限公司(原吳江市萬事達(dá)環(huán)保溶劑有限公司) ?? ?? ? 呉 ? ? 平望 ??, 99.6 ?? ?? ? ?? ?? 318 ??, ?? ?? ??? 頔 ? ? ??, ? 専 ? ?? ?? ??, ??? ?? ? ????, ?? ?? ? ?? ???.
??? ?? ?? ??, ?? ? ??? ??, ?? ?? ?? ?? ? ??, ?? ?? ?? ??? ?? ?? ?? ??, ??? ?? ?? ? ?? ?? ??? ??, ISO9001 ?? ?? ??? ?? ? ISO14001 ?? ?? ?? ?? ? OHSAS 18001 ?? ?? ?? ?? ?? ?? ?? ?? ?? ??? ?? ?? ????.
??? ?? ?? ? ?? ?? ?? S ??? ????? ?? ??? ??? ??? ??, ?? ??? ??? ???????, Durene, PMDA, ?? ? ?? ???? 1 - ?? ???? ナ ??? ナ ??? 2 - ?? ????, ナ ??? ナ ??? ????.??? ?? ?? ??, ??, ??, ??, ??, ?? ??, ?? ?? ?? ?? ??.
?? ?? ?? ?? ?? ? ?? ?? ?? ??? ??? ?? ?? ??? ?? ??.

??? ??
???? ???? ?? ?? ??? ???? ?? ?? ??? ????? ??? ?? ???? ?????

?? ??? ??? ????? ?? ???? ??? ???? ?? ??????.

??? ??? ?? ???? ??? ???? ?????? ? ?? ??? ??? ?????.

????? ?? ?? ??? ???? ?? ?? ?? ?? ??

?? ??? ?? ??負(fù)責(zé)
??? ?????? 4 ?? ??
?? ?? ??? ? ?? ? ??? ??, ?? ? ??? ???, ?? ??, ?? ?? ????, 1- ?? ????, 2- ?? ????, ???? ? S ???? ?? ? ??? ??
??? ??
???? ?? ??? ?? ?


? ??? ?? ?? ??? ?? ??? ? ?? ? ??? ???? ??, ?? ? ??? ???, ?? ??, ?? ?? ????, 1- ?? ????, 2- ?? ????, ???? ?? S ??? ?? ? ??? ???? ????.
?? ??
???, ?? ??, ??, ??


? ??? ?? ??? ??, ??? ???, ??? ? ?? ?? ? ??? ??? ???? ?? ??? ???? ???? ?? ?? ??? ?? ? ?? ???? ?????.
?? ??
?? ? ?? ??, ??? ?? ?? ???


? ??? ??? ??? ??? ?? ??? ?? ??? ???? ??? ?? ?? ? ?? ?? ???? ???? ??? ISO9001 ?? ?? ??? ??, ISO14001 ?? ?? ??? ?? ? OHSAS18001 ?? ?? ? ?? ?? ??? ??? ????? ?? ??? ??????. ??? ? ??? ??
??? ??
???? ?? ? ???


?? 20 ?? ?? ??? ????? ??? ???? ?? ??? ?? ??? ??? ??? ????? ??? ??? ????? ?? ??? ? ??? ??? ??????? ?? ???? ????. ?? ??? ??? ????? ?? ?, ??? ??, ??? ?????? ??, ??? ??? ?? ????.
??
??? ?? ???? ??
27
[ 2018-09 ]
??? ???? 2 ?? ?? ?? ??? ??? ??
??? 2 ?? ?? ?? ??? ?? ?? ?? (???)? ?? ?? ?? ?? ? ???...
03
[ 2017-11 ]
CHINACOAT2017 | Pengchen New M
2017-11-03 Pengchen ??? ?? ?? ?? ??? (CHINACOAT 2017)? 11 ?...
25
[ 2017-02 ]
2017 ?? ??? ??? ?? (Pengchen N
CAC2017 ??? ??? ??? ?? (??)?? ? 18 ? ?? ?? ?? ? ?? ?? ??? 3....
17
[ 2017-02 ]
??? ???? ?? ??? ???
2 ? 12 ? ??, Xuwei New District Conference ? Pengchen Specia...
??: ?? ? 呉 ? ? 平望 ? ?? (99.6 ?? ?? ? ?? ?? 318 ??)
??: +86-512-63680537 (??) ??: +86-512-63688189 ??: +86-13812979999 ???? ?: +86-13375160921 ? ??
Copyright(C)2020, Pengchen New Materials Technology Co., Ltd. All Rights Reserved. Supported by ChinaChemNet ChemNet Toocle Copyright Notice 備案序號:蘇ICP備17008233號
